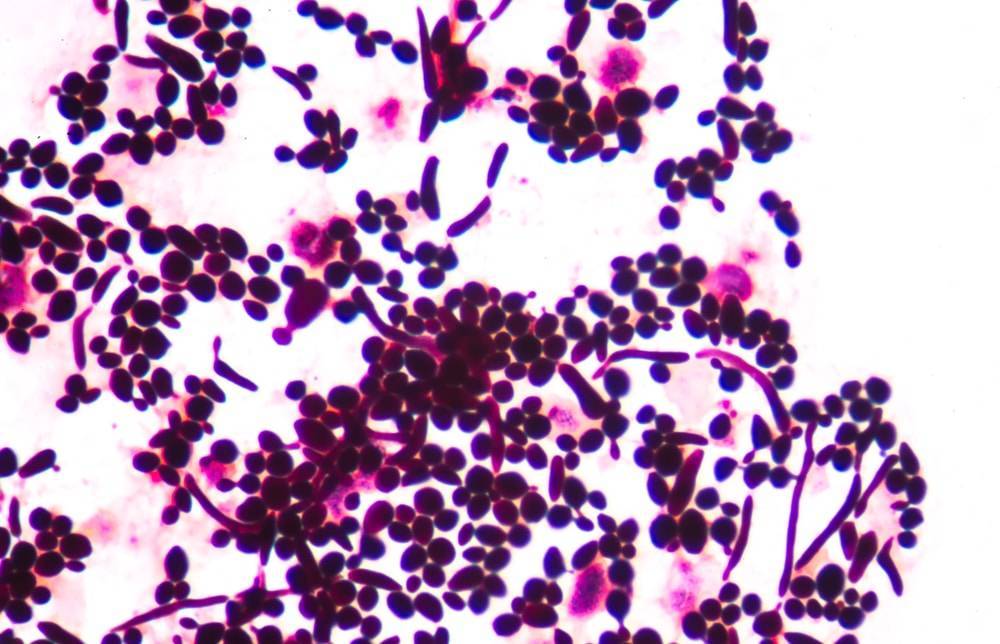

Несколько классическихрецептов
Список продуктов и пропорции для браги на
винных дрожжах и сахаре, как правило, стандартные и отличаются разве что
дополнительными ингредиентами. Наиболее распространенным является рецепт, где
предусмотрено использование варенья. В состав входят следующие компоненты:
- 20 литров воды. Можно менять количество, однако
строго соблюдать пропорции. Объем зависит от того, какое количество готового
алкоголя желает получить заготовщик, и может быть меньшим и большим; - 5 кг сахара, или другой объем, в соответствии
с первым пунктом; - непосредственно
продукт брожения; - любимое
варенье, используемое для подкормки.
Интересно:
Опытные производители самогона открыли секрет более активного и ускоренного
бродящего процесса, и советуют добавлять в качестве подкормки засахарившееся
фруктовое или ягодное варенье.
Брага
для самогона на винных дрожжах получится ароматной, чистой, приятной на вкус, если
придерживаться пошаговой инструкции ее заготовки. Сколько она бродит,
зависит от ряда факторов, в частности, от того, что добавляется в сусло, а
также от соответствия компонентов надлежащему качеству. Нельзя забывать, что
высококачественные компоненты не могут стоить дешево, и для получения
соответственного питья лучше потратиться немного больше.
Как
поставить брагу на винных дрожжах, разобраться несложно. Главное, строго следовать рекомендациям.
Таким образом, в первую очередь необходимо сварить сахарный сироп, потратив на
него четвертую часть воды. В бродильную емкость потребуется вылить полученный
сироп, затем долить оставшуюся воду, добавить подкормку, а также основной
компонент. Рецепт сахарной браги на
винных дрожжах предусматривает готовность не ранее чем через 5 дней, и не
более чем через 20. Более точно можно определить по звукам, издающимся из
емкости, а также по внешнему виду самой жидкости: она должна быть чистой, на
дне появится осадок, бурление и шипение прекратятся, поскольку углекислый газ
выделяться уже не будет.
Еще один способ получения отменного
алкоголя в домашних условиях, это перегонка бражки из зерен
Сколько винных дрожжей класть для такой браги, зависит от соотношения
остальных компонентов, но важно помнить о допустимом соотношении их с
жидкостью: примерно 1:10
Интересуясь вопросом, как заставить зерновую брагу на винных дрожжах, достаточно помнить
основные правила и технологию, используемую для создания питья, а также
определить оптимальный расчет необходимого объема зерна. Как правило, он
составляет 6-7 кг
на 30 литров
жидкости. Зерна потребуется тщательно промыть, желательно несколько раз и замочить
на несколько дней, перенеся в темное теплое место, чтобы оно проросло, после
чего перемолоть.
Важно:
При выборе тары следует учитывать, что зерно при набухании и проращивании
увеличивается в объеме, поэтому потребуется емкость с запасом на 15 сантиметров. Если
такой тары нет, следует уменьшить объем компонентов.С подготовленным зерном можно начинать готовить
закваску, перемешивая проросшее и перемолотое зерно с сахарным сиропом
Все
остальные действия осуществляются в соответствии с выбранной рецептурой:
добавляются все подготовленные ингредиенты с соблюдением последовательности,
накрываются и отправляются выстаиваться. Время от закваски до готовности
составляет не более недели.
Спиртовые дрожжи для самогона плюсы и минусы
Применение алкогольных или спиртовых дрожжей имеет ряд преимуществ перед хлебопекарными вариантами. Среди плюсов от использования такой культуры выделяют:
- Повышенная продуктивность работы.
- Увеличение концентрации спирта в браге до 18%, а обычные дрожжи погибают при 12-14%. Выход спирта после дистилляции будет больше.
- Процесс брожения ускоряется, брага на спиртовых дрожжах может созреть за 5 дней.
- Количество вредных примесей в напитке уменьшается, образуется меньше сивушных масел и альдегидов. А во время самого брожения образуется меньшее количество пены.
Существует несколько мифов по поводу деятельности этих культур. А также есть свои недостатки в использовании спиртовых штаммов:
- Время брожения сокращается, но при этом дрожжи погибают раньше. Срок готовности — от 5 до 7 дней.
- Пенообразование уменьшается только за счет сокращения времени брожения.
- Недостаток спиртовых дрожжей заключается в их непредсказуемости. Точно неизвестно, когда закончится брожение и продукт будет готов к перегонке, поэтому такую брагу нужно проверять чаще. За счет увеличения активности процесса сахарная брага на спиртовых дрожжах может быть готовой на третий день после постановки.
- Существует миф о том, что таких дрожжей нужно добавлять меньше. Если использовать сухие дрожжи, то это действительно так. Но если брать прессованный вариант, то количество хлебопекарной и спиртовой культуры получается одинаковым. Отзывы подтверждают, что сухие дрожжи для браги использовать выгоднее с точки зрения экономики.
А еще к недостаткам можно отнести необходимость покупки дрожжей в специализированных магазинах. Они есть не в каждом городе и поэтому покупка культуры может обойтись дороже и найти ее будет сложнее. Приобрести разновидность можно в магазинах для винокуров или поискать на рынках. Главное, следить за сроком годности продукта, особенно при покупке прессованных дрожжей. А если следовать всем тонкостям рецепта, то брага получится вкусной и относительно чистой.
Рецепт браги на спиртовых дрожжах допускает использование культуры с пометкой «турбо». Это означает, что в состав смеси добавлены аминокислоты. Обычно такие культуры стоят дороже. Аминокислоты играют роль подкормки для штаммов. Продукт удобно хранить, отмерять, особенно если турбо-дрожжи сухие. Одна чайная ложка таких дрожжей по активности заменяет 15 грамм свежих прессованных.
А еще важно сделать правильный выбор дрожжей для приготовления браги. Есть несколько стран-производителей, каждая выпускает товар разной активности и в разных пропорциях штаммов
Брага на белорусских спиртовых дрожжах готовится чаще всего из-за доступной стоимости продуктов. Вся информация, а также инструкции относительно количества дрожжей, пропорций и правила разведения содержатся на упаковке. Дрожжи классифицируются и по виду сусла для приготовления браги.
Рецепты
Брага и её рецепты различаются в зависимости от исходных составляющих. Самый простой рецепт браги для самогона тот, в котором не используется дополнительное сырьё. Для её приготовления нужно:
- Сахар – 1 килограмм.
- Дрожжи – 20 грамм.
- Вода – 5 литров.
Вода нагревается и в неё высыпается сахарный песок. Жидкость тщательно перемешивается. В это время дрожжи разводятся в небольшом количестве тёплой воды и добавляются в сироп.
Готовое сусло переливается в тару для брожения, надевается затвор и смесь выдерживается до готовности. Чтобы ускорить процесс, снизив время приготовления браги до 2 – 3 дней, в ёмкость кладётся нагреватель для аквариумов. Он должен постоянно поддерживать температуру 24 – 25 градусов. При отсутствии такого приспособления ёмкость заворачивается в несколько слоёв ткани и ставится возле батареи или любого другого бытового нагревателя. При таком подходе брожение затянется до одной недели и требует постоянного контроля температуры. Она не должна превышать 28 градусов.
Рецепт приготовления браги из варенья содержит 2,5 килограмма сладкого продукта. Причём из-за нового ингредиента из состава исключается сахар, а количество дрожжей снижается до 2 – 3 граммов. Варенье смешивается с водой и нагревается до 50 градусов. Приготовленная смесь остужается до комнатной температуры и смешивается с дрожжами. Смесь настаивается в тёмном месте в течение пары недель до появления признаков завершения брожения. Рецепт приготовления браги для самогона один из самых востребованных, так как многие часто делают заготовки на зиму, часть из которых остается невостребованной и ищет применения.
Способы приготовления браги для самогона могут и совсем не содержать дрожжей. В таких рецептах в качестве главного сырья применяется зерно. Для приготовления оно предварительно проращивается. Для рецепта нужно:
- Пшеница – 5 килограмм.
- Вода – 15 литров.
- Сахар – 6,5 килограммов.
Пшеницу нужно тщательно просеять высыпать в ёмкость и залить тёплой водой так, чтобы её уровень находился на 1 – 2 сантиметра над зёрнами. К ним нужно добавить 1,5 килограмма сахара и накрыть крышкой. После появления ростков пшеница заливается 15 литрами воды и засыпается остальным сахаром. Смесь настаивается полторы недели в тёплом месте под гидрозатвором.
Брага из вишни делается всего из 1 ингредиента. Ягоды отделяются от косточек, разминаются и заливаются небольшим количеством воды. Такая брага настаивается, как и виноградная, в тёплом месте до появления признаков готовности
Лучшие рецепты браги для самогона очень просты, не требуют много времени на подготовку к брожению и состоят из небольшого количества ингредиентов. Можно приготовить самогон даже на горохе. Для этого нужно:
- Вода – 15 литров.
- Сахар – 5 килограмм.
- Дрожжи – 60 грамм.
- Горох – 2 килограмма.
- Сметана – 200 грамм.
В ёмкости перемешиваются вода, дрожжи и горох. Смесь настаивается в течение часа. После этого к ней добавляется сахар и сметана. Все ингредиенты перемешиваются и бродят на протяжении 3 – 4 дней.
По сути, брагу для дальнейшей перегонки можно приготовить почти из любого подручного продукта. Это могут быть яблоки, арбуз, варенье, картофель, хлеб, зерно. Главное – соблюсти все нюансы для подготовки сусла и запуска процесса брожения и правильно определить момент её готовности.
Как приготовить дрожжи
Для приготовления винных дрожжей покупают изюм. Дрожжи из изюма готовятся по следующему рецепту:
- 1 столовая ложка сахара;
- 1 столовая ложка изюма;
- 0,4 литра воды.
В бутылку из стекла засыпают сахар, заливают кипяченой водой, взбалтывают, дают остыть до температуры в 30 градусов, добавляют изюм. Полученную смесь еще раз взбалтывают и помещают в теплое место для брожения. Степень готовности дрожжей проверяется спустя 5-6 дней. Готовыми дрожжи признаются при отсутствии в них подымающихся пузырьков газа. Винные дрожжи домашнего производства используют по назначению сразу после приготовления. Хранится такой продукт недолго.
В некоторых случаях в качестве винных можно использовать дикие дрожжи. Для приготовления таковых используют следующий рецепт:
- 2 стакана перетертых ягод винограда (свежих);
- 0,5 стакана сахара;
- 1 стакан воды.
Ингредиенты смешивают, помещают в банку, накрывают крышкой и оставляют на 4 дня в затененном месте в тепле. Готовые дрожжи процеживают через марлю, полученную жидкость используют для закваски браги. Хранить такие дрожжи можно не более 10 дней, они быстро прокисают и могут испортить вкус продукта. На 10 литров браги берут не менее 0,3 литра такой закваски.
Необходимые для закваски бактерии имеются и на покрывшемся белым налетом изюме. Для достижения такого эффекта покупается слегка слежавшийся изюм, помещается в теплое место на 2-3 дня и используется в качестве дрожжей для приготовления браги.
Технология приготовлениябраги

Основные правила приготовления бражки
позволят создать высококачественную заготовку, из которой получится чистый
самогонный напиток без неприятного резкого запаха и специфического вкуса,
достаточной крепости
В частности, важно помнить о следующих советах
специалистов:
при
использовании любого хлебного изделия, следует помнить, что основным его
составляющим компонентом, необходимым для создания качественной бражки,
является крахмал, и чтобы его расщепить, получив глюкозу, потребуется
использовать продукт, способствующий данному процессу;
лучшие рецепты браги из хлеба в домашних условиях подразумевают использование
солода или плесени для расщепляющей реакции крахмала, поскольку они самые
доступные и безопасные
Используя солод, получится добиться мягкости и
натуральности готового продукта;
используя
плесень, обязательно следует перегнать заготовку, и не употреблять ее в
качестве готового напитка, поскольку бактерии из плесени опасны для
человеческого организма и гибнут только при высокой температуре;
готовить
бражку можно на белом, черном,
ржаном, кукурузном и на смешанных хлебных изделиях, а также, используя сухари,
но при этом важно помнить об отличиях в технологических особенностях подготовки
к брожению заготовки для напитка;
все
продукты должны соответствовать высокому качеству, иначе готовый алкоголь будет
иметь неприятный запах или цвет, либо иные недостатки.. Не менее важным фактором является и способ
определения готовности продукта, о чем свидетельствует светлый цвет, наличие
осадка на дне тары, а также то, что перестал выделяться углекислый газ, что
будет понятно из отсутствия шипения и бурления из емкости с бражкой
Не менее важным фактором является и способ
определения готовности продукта, о чем свидетельствует светлый цвет, наличие
осадка на дне тары, а также то, что перестал выделяться углекислый газ, что
будет понятно из отсутствия шипения и бурления из емкости с бражкой.
Важно:
При строгом соблюдении правил приготовления бражка получится ароматная и не
будет иметь сторонних запахов. В результате готовый алкоголь будет отвечать
высокому качеству
Самогон из виноградного сырья
Главное отличие виноградной браги от вина — высокая скорость брожения и отсутствие необходимости в предварительной очистке сока от жмыха и косточек.
Ягоды не моют, поскольку на их поверхности содержится большое количество диких дрожжей, способствующих процессу брожения. Для ускорения дозревания браги рекомендуется дополнительно использовать 200 — 250 г прессованных или 100 г сухих спиртовых дрожжей.
Для лучшего брожения рекомендуется добавить дрожжи
Ягоды отделяют от плодоножек, после чего давят их вручную или при помощи специального пресса, который сохраняет целостность косточек. Использовать с этой целью мясорубку или кухонный комбайн не рекомендуется, поскольку подобные механизмы перемалывают не только ягоду, но и косточку, вследствие чего напиток получит терпкий вкус.
По окончанию брожения брагу тщательно фильтруют и перегоняют с обязательным отбором голов и хвостовых фракций. В случае необходимости самогон можно перегнать повторно, но в этом случае практически полностью пропадает присущий напитку приятный аромат и вкус.
Самогон из винограда — это не что иное, как коньячный спирт, который является главным компонентом для производства знаменитого французского напитка. Если настоять конечный продукт на дубовой коре или щепе, можно достичь максимального сходства с коньяком или качественным бренди. О том, как сделать зимнюю брагу из винограда смотрите в этом видео:
Еще одна разновидность виноградного самогона получила широкое распространение в странах, которые исторически являются ведущими винодельческими регионами. Грузинская чача и итальянская граппа готовятся из виноградного жмыха — отхода виноделия, получаемого в результате фильтрации сока. Жмых содержит достаточное для брожения количество питательных веществ, что позволяет получать из него вкусный и ароматный напиток.
Полученную брагу фильтруют и проводят двойную перегонку, после чего напиток можно употреблять как в чистом виде, так и в качестве ингредиента различных настоек.
Как понять, что брага готова
Индикаторами завершения процесса брожения служат:
- Прекращение выделения углекислого газа из гидрозатвора.
- Опадание перчатки, надетой на горловину ёмкости.
- Отсутствие сладости во вкусе.
- Отсутствие бульканья.
- Отсутствие образования пены и характерного шипения.
- Появление явного запаха спирта.
- Продолжающая горение над поверхностью браги спичка.
Если при приготовлении браги для самогона сохранилась сладость во вкусе, то значит, в технологии допущена ошибка. Может быть превышена норма сахара на одну порцию дрожжей. Из-за этого образовалось столько спирта, что действие дрожжей остановилось, а весь сахар не переработался. Для выхода из ситуации нужно добавить в брагу воды и ещё выдержать.
Другая ошибка – нарушение температурных условий. При установлении температуры ниже 20 градусов дрожжи перестают работать и сахар не расщепляется. В таком случае ёмкость со смесью переносят в более тёплое место.
После устранения ошибок нужно дождаться повторного появления признаков завершения брожения и только тогда считать напиток готовым к следующему этапу.
Осветление
Этот этап является завершающим и разделяет приготовление браги и сам процесс перегонки в кубе. Осветление выполняется для очищения браги от вредных примесей. Если этого не делать, то в процессе перегонки они будут сгорать в кубе и придадут самогону резкий неприятный запах.
Перед осветлением брага снимается с осадка или просто фильтруется через сито или дуршлаг. После этого делаем несколько пунктов:
- Охлаждаем тару с брагой до 5 градусов.
- Вливаем в ёмкость раствор бетонита.
- Настаиваем одни сутки.
- Вливаем размоченный желатин и держим ещё пару суток.
- Снимаем отслоившуюся чистую брагу так, чтобы не задеть осадок и не замутить им жидкость.
Бетонит размачивается теплой водой в небольшом количестве, желатин – в холодной и выдерживается до разбухания. После выполнения всех пунктов брага готова к дальнейшей перегонке.
Лучшие дрожжи для браги
Одной из самых главных составляющих хорошей браги служат правильно выбранные дрожжи. Исследования показали, что для самогоноварения лучше всего использовать спиртовые, хлебопекарные или дикие дрожжи. Именно они способны придать самогону по-настоящему глубокий насыщенный вкус и обеспечить ему нужную крепость.
Винные и пивные дрожжи часто встречаются в магазинах и стоят значительно дешевле, но приобретать их не рекомендуется, так как они обладают существенными недостатками. Уже из их названий понятно, что эти дрожжи куда больше подходят для приготовления других напитков. Если вы попытаетесь использовать для самогона винные дрожжи, то у вас ничего не получится без специального оборудования. Из пивных дрожжей самогон вы в конечном итоге все-таки получите, но в нем будет слишком много пены, и он не будет достаточно крепким.
Классический рецепт приготовления браги
Для того, чтобы приготовить брагу, вам потребуются 10 тиров воды, 2 килограмма сахара и около 200 грамм дрожжей. Сахар растворяется в разогретой воде, давая вам своеобразный сахарный сироп. Когда он остудится до 30-ти градусов, можно добавить в сусло дрожжи. Появление пены даст вам сигнал: пора перемешать заготовку и ставить ее на брожение.
В некоторых случаях в браге может образоваться слишком много пены, особенно если для ее изготовления все-таки были использованы не спиртовые, а пивные дрожжи. Помочь хоть как-то справиться с пеной может добавление в брагу нескольких капель растительного масла. Вступая с брагой в химическую реакцию, оно способно нейтрализовать почти все пенные выделения.
Гидрозатвор
Гидрозатвором профессионалы называют специальную заглушку, не дающую проникнуть в брагу бактериям из воздуха. Чаще всего выглядит такая заглушка очень просто и являет собой медицинскую перчатку, натянутую на тару с брагой. Если вы действительно будете использовать в роли гидрозатвора именно перчатку, не забудьте проткнуть ее иглой. Это обеспечит выход из емкости углекислого газа и поможет избежать взрыва, который уничтожит все плоды вашей работы.
Гидрозатвор играет еще одну важную роль — он показывает, когда процесс брожения подходит к концу. Как только перчатка перестает быть упругой и опадает, вы можете быть уверены, что ваш самогон готов.
Можно ли ускорить брожение?
Брожение — это процесс, на скорость которого, безусловно, можно и нужно влиять подручными средствами. И подкормка дрожжей, описанная выше — отнюдь не единственный способ более быстрого получения самогона. Например, добавление в брагу немытого изюма также способно оказать положительное влияние на скорость процесса. Много изюма при этом добавлять не нужно — достаточно всего одной горсти.
Регулярно помешивайте брагу — это тоже несколько увеличит скорость брожения за счет ликвидации излишек углекислого газа.
Следите за температурными условиями. Если в месте, в котором вы оставили настаиваться брагу, нет 27-ми градусов, процесс затянется. Идеальными условиями для брожения является температурный диапазон от 27-ми до 35-ти градусов.
Признаки готовности к перегонке
Существует несколько признаков, дающих производителю понять, что брага, наконец, готова и можно переходить к сцеживанию самогона. Проще всего определить это на вкус — полученная смесь должна быть горьковатой и оставлять после себя терпкое послевкусие.
Если вы в силу каких-то причин не горите желанием пробовать брагу на вкус или не можете определиться со своими вкусовыми ощущениями, доверьтесь обонянию. Запах должен утратить все прежние оттенки, сохранив только хорошо различимый запах этилового спирта.
Визуально напиток должен посветлеть и быть практически прозрачным. На его дне должен образоваться золотистый осадок.
Ликвидация осадка
Осадок, образующийся на дне браги, не пригоден к потреблению
Очень важно грамотно избавиться от него. Опытные самогонщики рекомендуют профильтровать брагу при помощи белой глины
Это уберет не только осадок, но и сократит объем произведенного алкоголя. Зато крепость вашего напитка ощутимо повысится, а осадок, портящий его вкусовые качества, будет полностью ликвидирован.
Быстрые рецепты браги
Очень часто у производителя нет времени ждать, пока осуществится полноценный процесс брожения. Специально для таких случаев профессионалами было разработано несколько срочных рецептов.
Самый популярный из них предполагает использование 6 килограмм сахара, 30 литров воды и около полу-килограмма дрожжей. Смесь требуется поставить в темное помещение с температурой от 35-ти градусов, и брага будет полностью готова всего через 3 дня.
В основе других срочных рецептов также лежит повышение температурного режима. Жаркие условия несколько влияют на вкусовые качества самогона, но скорость брожения они увеличивают надежно. Правда, специалисты все же не рекомендуют гнаться за срочностью. Уж лучше подождать немного больше времени, но в конечном итоге получить идеальный алкоголь.
Список источников
- alconation.ru
- samogonhik.ru
- how-to-drink.ru
- pogarchik.com
- samagon.win